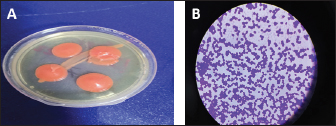

| Research Article | ||
Open Vet. J.. 2023; 13(6): 765-771 Open Veterinary Journal, (2023), Vol. 13(6): 765-771 Original Research Effect of laser radiation on the growth of Rhodotorula mucilaginosa isolated from rumin fluid of cows in the Nineveh, IraqHawraa F. H. Al-Abedi1*, Mumtaz M. M. Kasha1, Karrar A. Zaker1 and Inaam M. N. Alrubayae21Laser and Photonics Research Center, University of Al-Hamdaniya, Nineveh, Iraq 2Department of Biology, College of Science, University of Basrah, Basrah, Iraq *Corresponding Author: Hawraa F. H. Al-Abedi. Laser and Photonics Research Center, University of Al-Hamdaniya, Nineveh, Iraq. Email: Hawraafaisal [at] uohamdaniya.edu.iq Submitted: 07/03/2023 Accepted: 25/05/2023 Published: 17/06/2023 © 2023 Open Veterinary Journal
AbstractBackground: The fungi Rhodotorula species are widespread airborne contaminants and are thought to be natural occupants of human skin, lungs, urine, and feces. Therefore, Rhodotorula mucilaginosa, Rhodotorula minuta, and Rhodotorula glutinis are three of the most prevalent species. Aim: This study aims to isolate R. mucilaginosa from the rumen fluid of cows in the province of Mosul and to determine how laser light irradiation affects the growth and morphological traits of these Fungi. Methods: From the rumen fluid of AL-Restaki and AL-Karadi of cows, the R. mucilaginosa was isolated. Using the traditional approach and the ID-Yst card system Vitek 2. A semiconductor laser system with a power of 50 mW and a wavelength of 450 nm was used in the experiment to evaluate the light laser irradiation effects on the culture growth of R. mucilaginosa directly under two light irradiation conditions of 30 and 60 minutes. Results: According to traditional methods and the ID-Yst card system Vitek 2, R. mucilaginosa predominated 7/30 (23.3%), and these strains effectively grow on medium sabouraued dextrose agar as evidenced by the carotenoid pigments that gave their colonies a salmon-pink to coral-red. Compared with a control group where no laser was used, the impact of light laser irradiation was assessed 24 hours after the irradiation using biomass (dry weight measuring yeast cell content in suspension) and microscopic analysis using Gram stain. Microscopic examinations showed the irregular shape of the cells linked to one another. The irradiated subculture of on Sabouraued dextrose agar and incubation at 37°C for 3 days demonstrated inhibited growth in 4/7 (57.1%) isolates. In addition, there was no discernible difference vertically at p < 0.05 between the control group and the R. mucilaginosa biomass concentration under light irradiation circumstances (30 and 60 minutes). Conclusion: This study proved that R. mucilaginosa is found in the rumen fluid of cows. Also, the isolated R. mucilaginosa displayed sensitivity to laser irradiation lights, revealing the more significant topographical alterations of the cell structure that had happened, the irregular shape of the cells, and how they were connected as a result of evolution. Keywords: Laser application, Rhodotorula mucilaginosa, Rumen fluid of cow. IntroductionThe last few decades have seen a significant rise in fungal infections that require medical help. Although Aspergillus and Candida species are responsible for most of these infections, less frequent pathogens become responsible for many infections (Pfaller and Diekema, 2004). Several authors have referred to these fungi as “emerging pathogens.” Several of them historically have been regarded as contaminants in the laboratories or as being low virulent. These emerging pathogens include a variety of dematiaceous and hyaline molds and yeasts other than Candida species (Pfaller and Diekema, 2004; De Almeid et al., 2008). Rhodotorula spp. are opportunistic pathogens that can cause invasive infections in the right circumstances. This understanding developed, and approximately a hundred Rhodotorula infections cases have been reported in the previous 40 years (Lanzafame et al., 2001; Perniola et al., 2006). Species of the sporidiobolaceae family called Rhodotorula are colored basidiomycetous yeasts (Fell et al., 2000). That is, only 3 of the 37 species in this genus, including Rhodotorula mucilaginosa (previously Rhodotorula rubra), Rhodotorula glutinis, and Rhodotorula minuta, have been identified as human pathogens (Biswas et al., 2001; Miceli et al., 2011). Recently, three unique species that are not harmful to people were described Rhodotorula silvestris, Rhodotorula straminea, and Rhodotorula rosulata (Golubev et al., 2010). Most Rhodotorula species produce colonies on Sabouraud dextrose agar that are pink to coral in color, while some can also be orange or red due to the presence of carotenoid pigments (Fell et al., 2004; Wirth and Goldain, 2012). The colony shape is supple, smooth, wet, and occasionally mucoid. Also, in this context, Rhodotorula species are fungi that have quick growth rates, ease of growing on various media, and lack of dietary fastidiousness. Under a microscope, they appear as oval budding or round cells, and pseudohyphae and sometimes a faint capsule form around the cell. Rumen yeasts may not be crucial to rumen fermentation, but from a veterinary perspective, they may be significant as a source of infection (Zened et al., 2020). The three domains of life (bacteria, archaea, and eukaryotes), as well as viruses, are all represented in the very dense and diverse population of microbes found in the rumen (Zened et al., 2020). Bacteria dominate and perform the majority of the rumen’s metabolic tasks (1010–1011 cells per g of ruminal material), Protozoa (106 cells per g of ruminal fluid), which make up 30%–50% of the rumen’s microbial biomass, and fungi are examples of eukaryotes (105 zoospores per g of ruminal content) (Zened et al., 2020). Rhodotorula mucilaginosa has a probiotic effect and high nutritional value, The cell walls of R. mucilaginosa contain glucan and mannan, which can improve neutrophil and macrophage migration and phagocytosis, reduce intestinal inflammation, increase the resistance of animals, encourage the reproduction of helpful bacteria, and inhibit competitively the colonization of the harmful bacteria (Dalmo and Bogwald, 2008). Products made from R. mucilaginosa contain lots of carotenoids and zymochromes (Aksu and Eren, 2005). Previous research has demonstrated the advantages of carotenoids for animal and human health (Mannazzu et al., 2015). Carotenoids are known as super antioxidants because they regulate cell communication and gene expression, which helps them prevent cancer, block gene mutations, and fend off the impacts of environmental genotoxic chemicals (Dalmo and Bogwald, 2008; Bhagavathy and Sumathi, 2012). These perform various health-related tasks, such as boosting host defenses, exhibiting anti-oxidant and anti-tumor action, and decreasing blood pressure (Sharma and Ghoshal, 2020). Nevertheless, there are not many studies on using R. mucilaginosa in raising animals, and its safety hasn’t been established yet (Sharma and Ghoshal, 2020). Even though some yeast species may survive in the rumen and enter there with animal food, they are frequently regarded as transient, nonfunctional microorganisms in this ecosystem. The primary rumen environment conditions include pH values between 5.3 and 7.1, a temperature between 38°C and 40°C, a concentration of volatile fatty acids between 39 and 190 mmol l−1, and a humidity range between 82% and 90% (Vargas-Bello-Perez et al., 2016; Fernandes et al., 2019). By modifying the ruminal environment to make it more hospitable for microorganisms, yeast can operate as a growth booster. One of the yeast’s crucial functions is oxygen scavenging, which lowers the amount of oxygen in the rumen and increases the survival of other anaerobic microorganisms (Fonty, 2006; Sirisan et al., 2013). In several medical specialties, including dentistry, controlling infections brought on by bacteria and fungi is a significant difficulty. We urgently need to concentrate on finding new approaches to treat rapidly evolving medication resistance and recurrent candidiasis, which cannot be emphasized enough (Seyedmousavi et al., 2014). Photoantimicrobial therapy is superior to conventional therapies because it is safe, effective, and simple to use and because it has an activity spectrum that includes bacteria, fungi, viruses, and protozoa. Laser medicine development has produced several new therapy modalities capable of harming pathogenic organisms (Wainwright et al., 2017). Studies have shown that using lasers has antifungal and bactericidal effects (Seyedmousavi et al., 2014). Many organisms, including fungi and their secondary metabolites, can flourish because light is a crucial element (Kong et al., 2019). Only some lines of R. mucilaginosa produce capsules and pseudohyphae in the serum; most traces of R. mucilaginosa are in a position to make the biofilm in serum at 37°C in polystyrene microplates. However, the dimension of the biofilm after 3 days of incubation is extensively lower than in the contrast traces of Candida albicans(Pawl, 2010). In this study, R. mucilaginosa was isolated from the ruminal fluid of cows in the province of Mosul, and the effects of light laser irradiation on the morphological traits and growth of R. mucilaginosa were assessed. Material and MethodsAnimal experimentalThirteen 5-year-old AL-Restaki and AL-Karadi cows with an average weight of 600 kg were stabled in cubicles in the Cogley region, Mosul province, from December 2022 to February 2023. Isolating, identifying, and characterizing R. mucilaginosaRumen fluid samples from cows were collected 24 hours after food consumption and collected via a ruminal cannula in the ventral rumen sac in hermetically sealed sterile bottles for mycological analysis and immediately transported to the laboratory laser and photonics research center. Since all ruminal fluid samples were obtained from cow nutrition fed consisting of crushed wheat with bran, flour, and straw with a little yellow corn fed. Rhodotorula mucilaginosa isolated according to the methodology (Marrero et al., 2013; Alhasan et al., 2022). Isolation media include Sabouraud dextrose agar, supplemented with chloramphenicol (0.05 g/ml). Sabouraued dextrose broth was placed in each tube as 9 ml, and 1 ml of rumen fluid was added to the first tube and mixed well. Then 1 ml was added to a second tube from the first tube, and so on to obtain a tenfold serial dilution series (10−1 to 10−7). 1 ml was inoculated on Sabouraud dextrose agar from each dilution (10−3–10−5) and then incubated in the plate at 37°C for 3 days until a colony of R. mucilaginosa was obtained. The culture was examined macroscopically for colony character, growth rate, surface, reverse color, and colony uniformity. Gram staining was first utilized to examine positive fungus colonies microscopically (De Hoog and Guarro, 1996; Begum et al., 2020). Identification of R. mucilaginosa using the Vitek 2 system (BioMerieux, France) is a fully automated instrument for the identification of fungi. Laser applicationAn experimental study used the influence of light intensity exposure on the direct vertical for culture of R. mucilaginosa by a semiconductor laser system (450=nm wavelength and 50 mW power laser) under two duration of irradiation conditions vertically at a distance of 10 cm for 30 and 60 minutes (Fig. 1). Each culture irradiation was subculture on Sabouraued dextrose agar incubation at 37°C for 3 days. Dry weight of yeastMeasuring yeast concentration in suspension before and after exposure to laser irradiation was determined as follows. Select colony, inoculate in 40 ml of Sabouraued dextrose broth incubate at 37°C for 2 days (triplicate three independent experiments). After that, centrifuged at 2,000 g for 15 minutes, the supernatant fraction was decanted, the residue was washed with ice-cold water, then centrifuged at 2,000 g for 15 minutes and translated to the final yeast pellet to the culture plate, drying overnight at 35°C. Weigh a new culture plate, record the weight (W1), weigh dry yeast pellet on the culture plate, record weight 2 (W2), and calculate the yeast dry weight W=W2−W1 (Noumia et al., 2015).
Fig. 1. Laser Irradiated on the direct vertically at a distance of 10 cm for the culture of R. mucilaginosa by a semiconductor laser system (450=nm wavelength and 50 mW power laser). Statistical analysisThe results obtained from this study were entered and statistically analyzed by the social science statistical package version 23 for Windows software. The data are reported as mean ± SEM and were analyzed statistically using the ANOVA test followed by the least significant difference (LSD) multiple comparison test, and values of p < 0.05 were considered significant (Field, 2005). Ethical approvalA procedure authorized by the Ethical Council for Animal Research was employed to care for the cows used in this study (No=UM.VET.2022.035). ResultsIn this study, 7/30 (23.3%) isolated R. mucilaginosa from the fresh rumen fluid of cows. The results of the isolates of R. mucilaginosa exhibited by their colonies on SDA were able to produce carotenoid pigments conferring a salmon-pink to the coral-red color of colonies. Using Gram stain, R. mucilaginosa cells appeared Gram-positive buddy yeasts spheroidal to an oval-like without the rudimentary hyphae formation shown in Figure 2. The results obtained by the Vitek YST system for the identification of the total isolated R. mucilaginosa revealed that the percentage was 7/30 (23.3%).
Fig. 2. Rhodotorula mucilaginosa growth on Sabouraued dextrose agar at 37°C for 3 days, (A) A salmon-pink to the coral-red color of colonies (B) Gram stains- 1,000× (oil immersion), R. mucilaginosa cell appeared Gram-positive buddy yeasts spheroidal to oval like.
Fig. 3. (A) Gram staining of R. mucilaginosa before exposure to laser irradiation lights shows spheroidal to oval budding cells. (B) Gram staining of the same culture of R. mucilaginosa after exposure to laser irradiation lights, topographical changes of the cell structure occurred, irregular shape of cells and their connection with each other. Table 1. Statistical analysis of the effect of laser on biomass growth R. mucilaginosa after exposure to laser irradiation lights 30 and 60 minutes.
Fig. 4. Statistical analysis of biomass concentration of fungi under light irradiation conditions 30 and 60 minutes compared with the control group. Examined irradiated culture revealed using Gram staining it was observed the more considerable topographical changes of the cell structure occurred, irregular shape of cells and their connection with each other (Fig. 3). The irradiated culture subculture on sabouraued dextrose agar and incubation at 37°C for 3 days revealed some inhibition growth in 4/7 (57.1%) isolates. The biomass concentration of R. mucilaginosa under light irradiation conditions 30 and 60 minutes compared control group showed no significant difference vertically at p < 0.05. The results indicated that strong light intensity could inhibit the fungus growth. According to the report from Sakaki et al. (2001) (Table 1, Fig. 4). DiscussionYeasts are unicellular fungi that offer high-quality protein and vitamins for feeding rumen microbes and host animals (Paserakung et al., 2015). Rhodotorula species are widely distributed. It can be found in dairy products, lakes, the ocean, air, and soil. Moreover, it is a non-pathogenic colonizer of mammals, plants, and humans (like shrimps) (Capoor et al., 2014). Although there is a wealth of information regarding medical mycology in Iraq, it has never been the subject of any previous bibliographic study (Hussain et al., 2021). As a result, we chose to conduct our new research in Iraq because there are no studies on the isolation and identification of R. mucilaginosa from the rumen fluid of cows. Seven out of 30 of R. mucilaginosa (23.3%) isolates, the colonies it formed were orange-red, and the yield of carotenoids was very high, according to the findings of this study, which were determined by examining the colony’s characteristics, each individual’s morphology, by using the Vitek 2 system. Formerly regarded as contaminants, Rhodotorula species have gradually come to be understood as human diseases over the past two decades. Rhodotorula can cause severe and deadly invasive infections, although having less virulence than Trichosporon or Candida (Merkur and Hodge, 2002; Almeida et al., 2008). The proportion of each isolated R. mucilaginosa 7/30 (23.3%) in the current investigation was inconsistent with that reported in Brazil by Fernandes et al. (2019), who reported the isolation of one species of Rhodotorula dairenensis from the rumen of a cow. According to earlier research, feeds typically transfer yeasts into the rumen, and the ruminal microbiota’s composition varies depending on the diet and location (Sundset et al., 2009; Almeida et al., 2012; Henderson et al., 2015). Rhodotorula is a widespread genus found in various environmental samples, including soil, water, milk, fruit juices, and air samples. This species can assimilate glucose, sucrose, and galactose (Guaman and Carvajal, 2009). These variations in proportions between studies may be due to the different numbers of isolates included in each investigation and the expertise of laboratory researchers. However, various circumstances, including feed sources, roughage to concentrate ratios (R:C), and ruminant species, could lead to the discovery of new forms of yeast (Jimoh et al., 2011; Marrero et al., 2013). Given the experimental circumstances of the current work, R. mucilaginosa culture exposure to laser light irradiation caused substantial topographical modifications of the cell structure to occur in all isolates, as well as irregular cell shape and connections between individual cells. Four out of seven (57.1%) isolates showed some growth suppression after being subculture on sabouraued dextrose agar and exposed to radiation for 3 days (Kong et al., 2019), who concluded that exposure to light might change the growth traits and metabolite compositions of R. mucilaginosa, which suggested that photo-regulatory factors may exist in non-photosynthetic fungi that can manufacture carotenoids. Moreover, controlling the light may be a practical technique to manage the biosynthesis and creation of medicinal components in the pigmented microorganism. The biomass concentration of R. mucilaginosa under light irradiation settings 30 and 60 minutes compared to the control group in the current study evolutions revealed no significant difference, which is inconsistent with the study (Kong et al., 2019), they reported that, in contrast to the dark control, irradiation with 1,700 l× might stimulate the development and uptake of glucose by R. mucilaginosa, while the experiment with 3,500 l× showed some inhibitory effects. Some studies on the impact of laser radiation on bacteria and fungi indicate biostimulants or proliferative outcomes, theorizing that these effects are connected to modifications produced by increased energy intake provided by the radiation in the bacteria’s respiratory chain (Kawamoto et al., 2000). As a unique application in medical management, laser therapy is a potentially useful treatment for this. Due to the constantly developing usage of laser technology in numerous fields of medicine, laser therapy has become indispensable in medical science. ConclusionThis study proved that R. mucilaginosa is found in the rumen fluid of cows. Also, the isolated R. mucilaginosa displayed sensitivity to laser irradiation lights, revealing the more significant topographical alterations of the cell structure that had happened, the irregular shape of the cells, and how they were connected as a result of evolution. The R. mucilaginosa biomass concentration under conditions of light irradiation 30 and 60 minutes comparisons between the control group showed no discernible difference vertically at p < 0.05. Although the current study will bring some new material to our knowledge of medical mycology in Iraq, it must be regarded as tentative and in constant need of updating. Our findings imply a thorough investigation to determine the impact of laser irradiation on microorganisms and the mechanisms underlying such effect, which is important to research in the future. AcknowledgmentsWe would like to thank Dr. Thoalfiqar Ali Zaker, Laser and Photonics Research Center, University of Al-Hamdaniya, Nineveh, Iraq, who trained us in laser techniques and encouraged and helped us to perform this study. Conflict of interestThe authors declare that there is no conflict of interest. Authors’ contributionHawraa Faisal: Conception and design of the study, wrote the first draft of the manuscript and design figures. Mumtaz Mati and Karrar Ali: critically revised the manuscript, funding acquisition. Inaam Mohmood: Writing one of the topics and critically revising the manuscript. ReferencesAksu, Z. and Eren, A.T. 2005. Carotenoids production by the yeast Rhodotorula mucilaginosa: use of agricultural wastes as a carbon source. Process Biochem. 40, 2985–2991. Almeida, G.M.D.D., Costa, S.F., Melhem, M., Motta, A.L., Szeszs, M.W., Miyashita, F., Pierrotti, L.C., Rossi, F.V. and Burattini, M.N. 2008. Rhodotorula spp. isolated from blood cultures: clinical and microbiological aspects. Med. Mycol. 46, 547–556. Almeida, P.M.N., Duarte, E.R., Abrao, F.O., Freitas, C.E.S., Geraseev, L.C. and Rosa, C.A. 2012. Aerobic fungi in the rumen fluid from dairy cattle fed different sources of forage. Rev. Bras. Zootec. 41, 2336–2342. Alhasan, D.A., Al-Abedi, H.F., Hussien, T.J. and Ali, A.Q.M. 2022. Morphological detection of dermatophytes isolated from cattle in Wasit province. Iraqi. J. Vet. Sci. 36(I), 167–172. Begum, K., Shahid, M.S., Ferdoush, S. and Nur, F. 2020. Phenotypic identification and antifungal susceptibility of two Rhodotorula species isolated from dandruff samples. Dhaka Univ. J. Pharm. Sci. 19(2), 185–190. Bhagavathy, S. and Sumathi, P. 2012. Evaluation of antigenotoxic effects of carotenoids from green algae Chlorococcum human lymphocytes. Asian Pac. J. Trop. Biomed. 2, 109–117. Biswas, S.K., Yokoyama, K., Nishimura, K. and Miyaji, M. 2001. Molecular phylogenetics of the genus Rhodotorula and related Basidiomycetous yeasts inferred from the mitochondrial cytochrome b gene. Int. J. Syst. Evol. Microbiol. 51(3), 1191–1199. Capoor, M.R., Aggarwal, S., Raghvan, C., Gupta, D.K., Jain, A.K. and Chaudhary, R. 2014. Clinical and microbiological characteristics of Rhodotorula mucilaginosa infections in a tertiary-care facility. Indian J. Med. Microbiol. 32(3), 304–309. Dalmo, R.A. and Bogwald, J. 2008. β-glucan as conductors of immune symphonies. Fish Shellfish Immunol. 25, 384–396. De Hoog, G.S. and Guarro, J. 1996. Atlas of clinical fungi. Mycoses, 2nd ed. Utrecht, The Netherlands: Centraalbureau voor Schimmelcultures., vol. 39, no. 1–2, p: 71. De Almeida, G.M.D., Costa, S.F., Melhem, M., Motta, A.L., Szeszs, M.W., Miyashita, F., Pierrotti, L.C., Rossi, F. and Burattini, M.N. 2008. Rhodotorula spp. isolated from blood cultures: clinical and microbiological aspects. Med. Mycol. 46(6), 547–556. Field, A. 2005. Discovering statistics using SPSS for windows, 2nd ed. New York, NY: Sage. Fell, J.W., Boekhout, T., Fonseca, A., Scorzetti, G. and Statzell-Tallman, A. 2000. Biodiversity and systematics of basidiomycetous yeasts as determined by large-subunit rDNA D1/D2 domain sequence analysis. Int. J. Syst. Evol. Microbiol. 50(3), 1351–1371. Fell, J.W., Statzell-Tallman, A., Kurtzman, C.P. and Fell, J.W. 2004. The yeasts, a taxonomic study. Amsterdam, The Netherlands: Elsevier, pp: 800–827. Fernandes, T., Carvalho B.F., Mantovani, H.C., Schwan, R.F. and Avila, C.L.S. 2019. Identification and characterization of yeasts from bovine rumen for potential use as probiotics. J. Appl. Microbiol. 127, 845–855. Fonty G. and Chaucheyras-Durand F. 2006. Effects and modes of action of live yeasts in the rumen. Biologia 61, 741–750. Golubev, W.I. and Scorzetti, G. 2010. Rhodotorula rosulata sp. nov., Rhodotorula silvestris sp. nov. and Rhodotorula straminea sp. nov., novel myo-inositol-assimilating yeast species in the Microbotryomycetes. Int. J. Syst. Evol. Microbiol. 60(10), 2501–2506. Guamán, B.C. and Carvajal, B.J. 2009. Characterization and identification of isolates of carotenogenic yeast strains from several natural zones of Ecuador. Univ. Sci. 14, 187–197. Henderson, G., Cox, F., Ganesh, S., Jonker, A., Young, W. and Janssen, P.H. 2015. Rumen microbial community composition varies with diet and host, but a core microbiome is found across a wide geographical range. Sci. Rep. 5, 14567. Hussain, A.F., Hashim, H.R., Mohamed, T.A. and Abdel-Azeem, A.M. 2021 An annotated bibliography of medical mycology in Iraq: 1962-2021. Microb. Biosyst. 6(1), 2021–1035. Jimoh, S.O., Ado, S.A., Ameh, J.B. and Whong, C.M.Z. 2011. Characteristics and diversity of yeast in locally fermented beverages sold in Nigeria. Res. J. Biol. Sci. 6, 389–392. Kawamoto, K., Senda, N., Shimada, K., Itol, K., Hirano, Y. and Murai, S. 2000. Antibacterial effect of yellow He-Ne laser irradiation with crystal violet solution on Porphyromonas gingivalis: an evaluation using experimental rat model involving subcutaneous abscess. Lasers Med. Sci. 15, 257–262. Kong, W., Yang, S., Agboyibor, C., Chen, D., Zhang, A. and Niu, S. 2019. Light irradiation can regulate the growth characteristics and metabolites compositions of Rhodotorula mucilaginosa. J. Food Sci. Technol. 56(12), 5509–5517. Lanzafame, M., De Checchi, G., Parinello, A., Trevenzoli, M. and Cattelan, A.M. 2001. Rhodotorula glutinis-related meningitis. J. Clin. Microbiol. 39, 410. Marrero, Y., Burrola-Barraza, M.E., Castillo, Y., Basso, L.C., Rosa, C.A., Ruiz, O. and González-Rodríguez, E. 2013. Identification of Levica yeasts as a potential ruminal microbial additive. Czech J. Anim. Sci. 58(10), 460–469. Mannazzu, I., Landolfo, S., Lopes da Silva, T. and Buzzini, P. 2015. Red yeasts and carotenoid production: outlining a future for non-conventional yeasts of biotechnological interest. World J. Microbiol. Biotechnol. 31, 1665–1673. Merkur, A.B. and Hodge, W.G. 2002. Rhodotorula rubra endophthalmitis in an HIV positive patient. Br. J. Ophthalmol. 86, 1444–1445. Miceli, M.H., Díaz, J.A. and Lee, S.A. 2011. Emerging opportunistic yeast infections. Lancet Infect. Dis. 11(2), 142–151. Noumia, E., Snoussic, M., Noumie, I., Saghrounid, F., Aounia, M. and Valentinb, E. 2015. Phenotypic characterization and adhesive properties of vaginal Candida spp. strains provided by the CHU Farhat Hached (Sousse, Tunisia). Rev. Iberoam. Micol. 32(3), 170–179. Paserakung, A., Pattarajinda, V., Vichitphan, K. and Froetschel, M.A. 2015. Selection and identification of oleaginous yeast isolated from soil, animal feed and ruminal fluid for use as feed supplement in dairy cattle. Lett. Appl. Microbiol. 61, 325–332. Perniola, R., Faneschi, M.L., Manso, E., Pizzolante, M., Rizzo, A., Sticchi Damiani, A. and Longo, R. 2006. Rhodotorula mucilaginosa outbreak in neonatal intensive care unit: microbiological features, clinical presentation, and analysis of related variables. Eur. J. Clin. Microbiol. Infect. Dis. 25, 193196. Pfaller, M.A. and Diekema, D.J. 2004. Rare and emerging opportunistic fungal pathogens: concern for resistance beyond Candida albicans and Aspergillus fumigatus. J. Clin. Microbiol. 42, 44194431. Pawl, K. 2010. Evaluation of selected virulence factors of Rhodotorula fungi. Available via http://www.dl.cm-uj.krakow.pl:8080/dlibra/publication/835/edition/835/content (Accessed 10 January 2023). Sakaki, H., Nakanishi, T., Tada, A., Miki, W. and Komemushi, S. 2001 Activation of torularhodin production by Rhodotorula glutinis using weak white light irradiation. J. Biosci. Bioeng. 92, 294–297. Seyedmousavi, S., Hashemi, S.J., Rezaie, S., Fateh, M., Djavid, G.E., Zibafar, E., Morsali, F., Zand, N., Alinaghizadeh, M. and Ataie-Fashtami, L. 2014 Effects of low-level laser irradiation on the pathogenicity of Candida albicans: in vitro and in vivo study. Photomed. Laser Surg. 32(6), 322–329. Sharma, R. and Ghoshal, G. 2020. Optimization of carotenoids production by Rhodotorula mucilaginosa (MTCC-1403) using agro-industrial waste in bioreactor: a statistical approach. Biotechnol. Rep. 25, e00407. Sirisan, V., Pattarajinda, V., Vichitphan, K. and Leesing, R. 2013. Isolation, identification and growth determination of lactic acid-utilizing yeasts from the ruminal fluid of dairy cattle. Lett. Appl. Microbiol. 57, 102–107. Sundset, M.A., Edwards, J.E., Cheng, Y.F., Senosiain, R.S., Fraile, M.N., Northwood, K.S., Praesteng, K.E., Glad, T., Mathiesen, S.D. and Wright, A.D. 2009. Molecular diversity of the rumen microbiome of Norwegian reindeer on natural summer pasture. Microb. Ecol. 57, 335–348. Vargas-Bello-Perez, E., Cancino-Padilla, N. and Romero, J. 2016.Technical note: use of internal transcribed spacer for ruminal yeast identification in dairy cows. Animal 10, 1949–1954. Wainwright, M., Maisch, T., Nonell, S., Plaetzer, K., Almeida, A., Tegos, G.P. and Hamblin, M.R. 2017. Photoantimicrobials—are we afraid of the light? Lancet Infect. Dis. 17(2), e49–e55. Wirth, F. and Goldani, L.Z. 2012. Epidemiology of Rhodotorula: an emerging pathogen. Interdiscip. Perspect. Infect. Dis. 2012, 465717. Zened, A., Forano, E., Delbes, C., Verdier-Metz, I., Morgavi, D. and Popova M. 2020. Ruminant microbiotas state of research and effects on animal performance and health. INRAE Prod. Anim. 33(4), 249–260. | ||
| How to Cite this Article |
| Pubmed Style Al-abedi HF, Kasha MM, Zaker KA, Alrubayae IM. Effect of laser radiation on the growth of Rhodotorula mucilaginosa isolated from rumen fluid of cows in the Nineveh, Iraq. Open Vet. J.. 2023; 13(6): 765-771. doi:10.5455/OVJ.2023.v13.i6.11 Web Style Al-abedi HF, Kasha MM, Zaker KA, Alrubayae IM. Effect of laser radiation on the growth of Rhodotorula mucilaginosa isolated from rumen fluid of cows in the Nineveh, Iraq. https://www.openveterinaryjournal.com/?mno=145643 [Access: January 25, 2026]. doi:10.5455/OVJ.2023.v13.i6.11 AMA (American Medical Association) Style Al-abedi HF, Kasha MM, Zaker KA, Alrubayae IM. Effect of laser radiation on the growth of Rhodotorula mucilaginosa isolated from rumen fluid of cows in the Nineveh, Iraq. Open Vet. J.. 2023; 13(6): 765-771. doi:10.5455/OVJ.2023.v13.i6.11 Vancouver/ICMJE Style Al-abedi HF, Kasha MM, Zaker KA, Alrubayae IM. Effect of laser radiation on the growth of Rhodotorula mucilaginosa isolated from rumen fluid of cows in the Nineveh, Iraq. Open Vet. J.. (2023), [cited January 25, 2026]; 13(6): 765-771. doi:10.5455/OVJ.2023.v13.i6.11 Harvard Style Al-abedi, H. F., Kasha, . M. M., Zaker, . K. A. & Alrubayae, . I. M. (2023) Effect of laser radiation on the growth of Rhodotorula mucilaginosa isolated from rumen fluid of cows in the Nineveh, Iraq. Open Vet. J., 13 (6), 765-771. doi:10.5455/OVJ.2023.v13.i6.11 Turabian Style Al-abedi, Hawraa F., Mumtaz M. Kasha, Karrar A. Zaker, and Inaam M. Alrubayae. 2023. Effect of laser radiation on the growth of Rhodotorula mucilaginosa isolated from rumen fluid of cows in the Nineveh, Iraq. Open Veterinary Journal, 13 (6), 765-771. doi:10.5455/OVJ.2023.v13.i6.11 Chicago Style Al-abedi, Hawraa F., Mumtaz M. Kasha, Karrar A. Zaker, and Inaam M. Alrubayae. "Effect of laser radiation on the growth of Rhodotorula mucilaginosa isolated from rumen fluid of cows in the Nineveh, Iraq." Open Veterinary Journal 13 (2023), 765-771. doi:10.5455/OVJ.2023.v13.i6.11 MLA (The Modern Language Association) Style Al-abedi, Hawraa F., Mumtaz M. Kasha, Karrar A. Zaker, and Inaam M. Alrubayae. "Effect of laser radiation on the growth of Rhodotorula mucilaginosa isolated from rumen fluid of cows in the Nineveh, Iraq." Open Veterinary Journal 13.6 (2023), 765-771. Print. doi:10.5455/OVJ.2023.v13.i6.11 APA (American Psychological Association) Style Al-abedi, H. F., Kasha, . M. M., Zaker, . K. A. & Alrubayae, . I. M. (2023) Effect of laser radiation on the growth of Rhodotorula mucilaginosa isolated from rumen fluid of cows in the Nineveh, Iraq. Open Veterinary Journal, 13 (6), 765-771. doi:10.5455/OVJ.2023.v13.i6.11 |